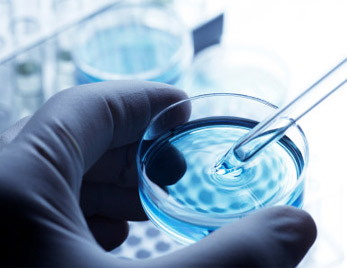
tratamiento esterilidad

La visita al ginecólogo cuando el embarazo tarda
Estudios de esterilidad y tratamientos para combatirla
Hay parejas que se deciden antes y otras que son más reticentes, quizás por pudor o vergüenza, pero lo aconsejable es visitar a un especialista ante la cualquier sospecha de estar sufriendo problemas para concebir.
Como explica el ginecólogo especialista en medicina reproductiva Israel Ortega, médico del IVI, generalmente se nos realizarán preguntas para conocer nuestra historia clínica y cuestiones como:
-
Estado de salud general y antecedentes personales de los pacientes: como enfermedades de base, alergias, cirugías previas, presencia de posibles infecciones y toma medicamentos en el momento en el que se está intentando concebir
-
Historia familiar: se estudian los antecedentes de cáncer, trombofilias, migrañas, enfermedades inmunológicas o casos de retraso mental.
-
Historia ginecológica: edad de la primera regla, ciclo menstrual, presencia o no de dolor con las reglas y uso previo de anticonceptivos.
-
Historia obstétrica: paridad anterior y tiempo de concepción fundamentalmente. En caso de abortos previos, nos preguntarán sobre la edad gestacional en la que ocurrieron los mismos, presencia o no de latido cardíaco y si se realizó o no legrado evacuador para la resolución del mismo.
- Factores ambientales: ocupación actual, además de estudiar si la pareja consume tabaco y drogas.
Cómo es el estudio básico de esterilidad
Más tarde se realizan las pruebas del estudio básico de esterilidad, que son las siguientes:
- Analítica general, con hemograma, bioquímica, coagulación y grupo sanguíneo. Siempre deben incluirse las serologías (pruebas de VHB, VHC y VIH) de ambos miembros de la pareja
- Determinación de hormonas basales en el tercer día de la regla. Esta prueba nos dará información sobre la reserva ovárica de la paciente, al mismo tiempo que permite valorar otras hormonas con un papel clave en reproducción, tales como la prolactina y hormonas tiroideas
- Ecografía, encaminada a valorar la integridad anatómica del aparato reproductor femenino.
- Seminograma, valorando la concentración, movilidad y morfología de los espermatazoides presentes en la muestra de eyaculado tras 3-5 días de abstinencia sexual.
En función de los resultados obtenidos con estas pruebas y de cada caso en particular, se pueden indicar estudios complementarios, como:
- Histerosalpingografía. Se realiza para el estudio de las trompas, necesario para poder realizar una inseminación artificial
- Histeroscopia. Está indicado en caso de presencia de pólipos o miomas submucosas que necesiten ser extirpados.
- Test de fragmentación del ADN. Se estudian los espermatozoides para profundizar en el estudio del factor masculino.
Tratamientos de la infertilidad
En el caso de Gema Trigueros las pruebas consistieron en "un análisis completo y exhaustivo con análisis de sangre y ginecológico para detectar posibles problemas, que en mi caso resultó ser infertilidad precoz. Además a él, le tuvieron que hacer una extracción de testicular de esperma (TESA), puesto que tenía una vasectomía hecha hace más de 20 años, por lo que es muy poco fiable invertir el proceso".
Los principales tratamientos que siguen las parejas para intentar traer un hijo al mundo, deben ser indicados de manera individualizada una vez llevado a cabo el estudio básico de esterilidad. Entre ellos, cabe destacar:
-
Coitos programados.
Consiste en mantener relaciones sexuales en determinados días tras tratamiento inductor de la ovulación.
-
Inseminación artificial
Es la introducción de muestra de semen capacitada dentro del útero de la mujer. Es necesario la presencia de una buena calidad seminal y permeabilidad tubárica para su realización.
-
Fecundación in vitro.
Consiste en la hiperestimulación ovárica controlada mediante el uso de hormonas con el fin de crear el desarrollo de múltiples folículos. A continuación se extraen los ovocitos mediante una punción ovárica, para ser posteriormente fecundados por los espermatozoides. Esta técnica está indicada en aquellos casos con factor masculino severo, muestras valiosas de semen, obstrucción tubárica y baja reserva ovárica, entre otros.
-
Donación de gametos.
Está indicada en aquellos casos en los que existe mala calidad ovocitaria o espermática, tratamiento radioterápico o quimioterápico previo, fallo ovárico precoz, cirugías previas, disgenesias (anomalías embrionarias que impiden la maduración de ovarios o testículos) y menopausia, entre otros.
Infertilidad: un tratamiento para cada pareja
Generalmente se suelen recetar medicamentos para la fertilidad combinados con inseminación artificial o técnicas de reproducción asistida como la fertilización in vitro, lo que incrementa las posibilidades de embarazo. Si los fármacos para aumentar la producción de óvulos se combinan con la inseminación artificial el porcentaje de éxito se sitúa entre el 8 y el 17 por ciento por ciclo.
En el caso de Gema Trigueros, se optó por la fecundación in vitro: "Comenzamos el tratamiento de fertilidad, pinchándome diferentes medicamentos para estimular la producción de óvulos para luego poder fecundarlos"
Gema aconseja a las parejas que si llevan más de un año intentándolo, desde luego acudan a consulta: "La pena es que la Seguridad Social, no te ayuda si tu edad ronda los 40; en mi caso después de un año de marearme, cuando me pusieron en lista tenía 38 y medio y directamente me dijeron que me fuera a la privada, porque la espera era de mínimo dos años."
El ginecólogo especialista en medicina reproductiva Israel Ortega, médico del IVI tiene claro que es necesario un estudio básico de esterilidad para llevar a cabo un diagnóstico preciso de cado caso y así poder orientar sobre el tratamiento a realizar de manera individualizada. "El factor tiempo en reproducción es clave, de modo que un retraso en el comienzo de dicho estudio puede empeorar el pronóstico reproductivo de la pareja y por tanto reducir las posibilidades de conseguir una gestación en un futuro"
Por eso es importante ponerse en manos de un especialista lo antes posible si una pareja está intentando traer a un hijo al mundo. Ante cualquier duda o problema en el intento de concepción lo mejor es consultar al médico.